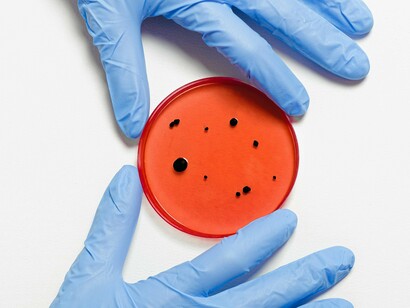
A tecnologia produz mosquitos infectados com Wolbachia, uma bactéria que bloqueia o desenvolvimento de vírus dentro do Aedes aegypti, impedindo sua transmissão. Inicialmente, esses mosquitos foram produzidos em pequena escala na biofábrica da Fiocruz, no Rio de Janeiro. Com a expansão do método, o Ministério da Saúde busca tornar o controle de arbovírus mais eficiente, superando o modelo tradicional focado exclusivamente em inseticidas
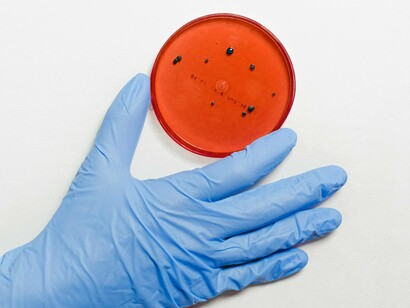
A Wolbachia está presente em 60% dos insetos e, quando injetada no Aedes aegypti durante estudos, impediu o desenvolvimento da dengue, zika, chikungunya e outros vírus arbovírus. Isso reduziu a transmissão dessas doenças. Quando mosquitos com Wolbachia são liberados no meio ambiente, eles se reproduzem com mosquitos selvagens. Isso produz uma nova geração com menor capacidade de transmitir esses arbovírus. Com o tempo, a proporção de mosquitos infectados com a bactéria aumenta e substitui a cepa selvagem, eliminando a necessidade de novas liberações

A luta contra a dengue e outras doenças causadas por arbovírus alcançou um novo marco. Foi inaugurada a maior biofábrica do mundo especializada na criação de mosquitos Aedes aegypti com a bactéria Wolbachia, a Wolbito do Brasil 1-2. A instalação está localizada na Cidade Industrial de Curitiba. Foi inaugurada oficialmente em 19 de julho de 2025, com a presença do ministro da Saúde, Alexandre Padilha. A biofábrica é fruto de uma colaboração entre o Instituto de Biologia Molecular do Paraná (IBMP) e o World Mosquito Program (WMP), uma organização global sem fins lucrativos. O Método Wolbachia foi desenvolvido pelo Ministério da Saúde (MS), pela Fiocruz e pelo WMP. Até o momento, ele já beneficiou aproximadamente 5 milhões de brasileiros. Espera-se que esse número chegue a 70 milhões nos próximos anos, já que o MS incorporou o Método Wolbachia como uma de suas estratégias nacionais de combate aos arbovírus. O IBMP é uma parceria entre a Fiocruz e o Governo do Paraná.
O Ministério da Saúde adotou estratégias baseadas em evidências científicas e tecnologias inovadoras focadas na redução das mortes por arbovírus. Elas estão organizadas em seis áreas: prevenção; vigilância; controle de vetores; organização da rede de saúde; preparação e resposta a emergências; e comunicação e participação da comunidade.
A tecnologia produz mosquitos infectados com Wolbachia, uma bactéria que bloqueia o desenvolvimento de vírus dentro do Aedes aegypti, impedindo sua transmissão. Inicialmente, esses mosquitos foram produzidos em pequena escala na biofábrica da Fiocruz, no Rio de Janeiro. Com a expansão do método, o Ministério da Saúde busca tornar o controle de arbovírus mais eficiente, superando o modelo tradicional focado exclusivamente em inseticidas.
A Wolbachia está presente em 60% dos insetos e, quando injetada no Aedes aegypti durante estudos, impediu o desenvolvimento da dengue, zika, chikungunya e outros vírus arbovírus. Isso reduziu a transmissão dessas doenças. Quando mosquitos com Wolbachia são liberados no meio ambiente, eles se reproduzem com mosquitos selvagens. Isso produz uma nova geração com menor capacidade de transmitir esses arbovírus. Com o tempo, a proporção de mosquitos infectados com a bactéria aumenta e substitui a cepa selvagem, eliminando a necessidade de novas liberações.
A Wolbito do Brasil atende à crescente demanda nacional pelo Método Wolbachia, que se tornou uma política de saúde pública do Ministério da Saúde. Ocupa uma área de mais de 3.500 m², possui equipamentos de última geração para automação e criação de mosquitos Wolbachia, além de uma equipe de cerca de 70 funcionários. Inicialmente, a unidade atenderá exclusivamente ao Ministério da Saúde. Isso garantirá que os mosquitos Wolbito sejam distribuídos para as diversas regiões do Brasil que apresentam alta incidência de dengue.
A Fiocruz está preocupada com o impacto dos arbovírus no país. Por isso, continua desempenhando seu papel como instituição científica e tecnológica que promove a saúde pública dentro do Sistema Único de Saúde (SUS). A inauguração da fábrica em Curitiba faz parte do esforço nacional para controlar o Aedes aegypti e combater os arbovírus (vírus transmitidos por artrópodes) que causam doenças como dengue, zika e chikungunya, transmitidas por mosquitos, principalmente o Aedes aegypti e o Aedes albopictus.
A Wolbito do Brasil foi criada para consolidar e expandir a implementação do Método Wolbachia no Brasil, sob a coordenação do WMP. Ela está presente em 14 países. A biofábrica Wolbito terá capacidade para produzir 100 milhões de ovos de mosquito por semana. O objetivo é reduzir drasticamente o número de casos de arbovírus no país. Em dez anos, ela terá beneficiado mais da metade da população brasileira. O Método Wolbachia está em uso no Brasil há pouco mais de dez anos, com resultados positivos. Em Niterói (RJ), por exemplo, a primeira cidade do país a ser totalmente coberta pelo método, a redução nos casos de dengue chegou a 69%.
Até o momento, o método foi implementado pela WMP em oito cidades: Niterói (RJ), Rio de Janeiro (RJ), Londrina (PR), Foz do Iguaçu (PR), Campo Grande, Joinville (SC), Belo Horizonte e Petrolina (PE). Atualmente, está sendo implementado em Presidente Prudente (SP), Uberlândia (MG) e Natal (RN). Outros municípios estão se preparando para começar a trabalhar com a Wolbito do Brasil, como Balneário Camboriú e Blumenau, além de novas áreas em Joinville, Santa Catarina; Valparaíso de Goiás e Luziânia, Goiás; e Brasília. Os três municípios de Santa Catarina, os dois de Goiás e Brasília estão, neste momento, na fase de comunicação e engajamento. A liberação dos Wolbitos nestas regiões ocorrerá ainda no segundo semestre. Os municípios são escolhidos por meio de um cuidadoso processo de seleção pelo Ministério da Saúde. A implementação está sendo realizada pela Wolbito do Brasil. Ela conta com o apoio estratégico da Fiocruz.
Ao reduzir o número de casos de doenças arbovirais, o Método Wolbachia também economizará dinheiro. Para cada R$ 1,00 investido, o governo economizará entre R$ 43,45 e R$ 549,13 em medicamentos, hospitalizações e tratamentos. Observe também que o Método Wolbachia não utiliza mosquitos geneticamente modificados. Ele é complementar a outros métodos, incluindo as precauções básicas que as comunidades devem tomar para eliminar os criadouros de mosquitos. O método é seguro, natural e autossustentável. A comunicação e o envolvimento extensivos com uma população bem informada e engajada produzem excelentes resultados.
A equipe da Wolbito trabalha com os governos locais em uma série de atividades informativas e educativas em escolas, centros de saúde, espaços públicos e associações comunitárias antes de soltar os mosquitos. Campanhas educativas também são realizadas em estações de rádio e TV locais, mídias sociais, mídia impressa e em mesas redondas com os residentes para garantir que as pessoas entendam o que é o método, como funciona e qual será o seu impacto.
Após a fase de comunicação e engajamento, os Wolbitos são liberados nas cidades. As liberações são geralmente realizadas semanalmente sob a responsabilidade de uma equipe técnica especializada, utilizando seus próprios veículos e equipamentos. A expectativa é que, ao longo dos meses, a presença da Wolbachia aumente de forma natural e constante em cada cidade selecionada.
O desenvolvimento do Método Wolbachia para controle de arbovírus começou em 2008 na Universidade Monash, em Melbourne, Austrália. O CEO da Wolbito, Luciano Moreira, então pesquisador da Fiocruz, participou do estudo que levou à descoberta científica. Na época, a Wolbachia era extraída de moscas-das-frutas e inserida no Aedes aegypti. Hoje isso não é mais necessário, pois os mosquitos são criados a partir de descendentes dessas moscas. A WMP iniciou estudos no Brasil em 2012, após a decisão da Fiocruz de trazer o Método para o Brasil. Em 2014, começaram as liberações em áreas-piloto: dois bairros nas cidades do Rio de Janeiro e Niterói, Tubiacanga e Jurujuba, respectivamente. Foi a partir desses dois locais que o Método foi expandido nacionalmente, com investimentos da Fiocruz em suas diversas fases ao longo dos anos.
O controle da dengue, zika e chikungunya beneficiará 140 milhões de brasileiros nos próximos anos. A Wolbachia está começando a ser produzida em massa no Brasil. O anúncio foi feito pelo ministro da Saúde, Alexandre Padilha, durante a inauguração, em Curitiba (PR), da maior biofábrica do mundo dedicada a atender às demandas do Ministério da Saúde. A fábrica é resultado de uma parceria entre a Fiocruz, a Wolbito do Brasil, o Instituto de Tecnologia do Paraná (Tecpar), o Instituto de Biologia Molecular do Paraná (IBMP) e o WMP, com um investimento de mais de R$ 82 milhões. A nova biofábrica produzirá 100 milhões de ovos por semana. Ela ampliará o alcance de cerca de 5 milhões de pessoas para 140 milhões em aproximadamente 40 municípios. Essa iniciativa torna o Brasil globalmente proeminente no controle de arbovírus.
O Brasil foi o primeiro país a oferecer a vacina contra a dengue pelo Sistema Único de Saúde (SUS). Até o momento, mais de 16 milhões de doses foram adquiridas para distribuição em todo o país. Para ampliar a oferta do imunizante e fortalecer a capacidade produtiva nacional, está prevista para 2026 a produção da vacina pelo Instituto Butantan, com a capacidade anual de 60 milhões de doses. A vigilância também segue ativa no país, com a rede nacional de laboratórios públicos mantida e equipada para confirmar casos, identificar os sorotipos do vírus da dengue em circulação e realizar vigilância genômica, com divulgação pública dos resultados para maior transparência e controle da doença.
Notas
1 Agência Fiocruz de Notícias e Básica Comunicações. Brasil inaugura a maior biofábrica do mundo de mosquitos Wolbitos para o combate à dengue e a outras arboviruses., 2025. Brasil inaugura a maior biofábrica do mundo de mosquitos Wolbitos para o combate à dengue e a outras arboviroses | Portal Fiocruz.
2 Vanessa Aquino, Ministério da Saúde. Governo Federal. Ministério da Saúde inaugura a maior biofábrica de Wolbachia do mundo, 2025. Ministério da Saúde inaugura a maior biofábrica de Wolbachia do mundo.